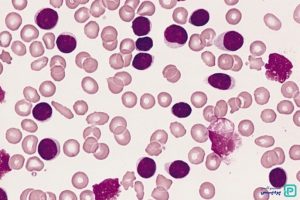

بیماری ها
لوسمی لنفوسیتی مزمن (Chronic Lymphocytic Leukemia) چیست؟
سرطان زمانی شروع میشود که سلولها شروع به رشد خارج از کنترل کنند. تقریباً سلولهای هر قسمت از بدن میتوانند به سرطان تبدیل شوند و به سایر قسمتهای بدن گسترش یابند. لوسمی لنفوسیتی مزمن (CLL یا Chronic lymphocytic leukemia) شایع ترین لوسمی در بزرگسالان است. این بیماری نوعی سرطان است که در سلولهایی شروع میشود که به گلبولهای سفید خاصی (به نام لنفوسیتها یا lymphocytes) در مغز استخوان تبدیل میشوند. سلولهای سرطانی (لوسمی) از مغز استخوان شروع شده اما سپس وارد خون میشوند.
در CLL، سلولهای لوسمی اغلب به آرامی ساخته میشوند. بسیاری از افراد حداقل برای چند سال هیچ علامتی ندارند. اما با گذشت زمان، سلولها رشد میکنند و به سایر قسمتهای بدن از جمله غدد لنفاوی، کبد و طحال گسترش مییابند.
لوسمی (leukemia) چیست؟
لوسمی سرطانی است که در سلولهای خون ساز مغز استخوان شروع میشود. وقتی یکی از این سلولها تغییر میکند و تبدیل به سلول لوسمی میشود، دیگر آنطور که باید بالغ نمیشود و خارج از کنترل رشد میکند. اغلب، برای ساختن سلولهای جدید سریعتر از حد معمول تقسیم میشود. همچنین سلولهای لوسمی در زمانی که باید بمیرند، نمیمیرند. این زنده مانی به آنها اجازه میدهد تا در مغز استخوان تجمع کنند و سلولهای طبیعی را از بین ببرند. در برخی مواقع، سلولهای سرطانی خون از مغز استخوان خارج شده و به جریان خون میپیوندند. این اتفاق باعث افزایش تعداد گلبولهای سفید در خون میشود. سلولهای لوسمی وقتی وارد خون میشوند میتوانند به سایر اندامها گسترش پیدا کنند، جایی که میتوانند از عملکرد طبیعی سایر سلولهای بدن جلوگیری کنند.
سرطان خون با انواع دیگر سرطانها که از اندامهایی مانند ریه، روده بزرگ یا سینه شروع میشود و سپس به مغز استخوان گسترش مییابند، متفاوت است. سرطانهایی که از جای دیگری شروع میشوند و سپس به مغز استخوان گسترش مییابند، سرطان خون نیستند.
دانستن نوع دقیق لوسمی به پزشکان کمک میکند تا چشم انداز هر بیمار را بهتر پیش بینی کرده و بهترین درمان را برای وی انتخاب کنند.
لوسمی مزمن (chronic leukemia) چیست؟
در لوسمی مزمن، سلولها میتوانند تا حدودی بالغ شوند (و بیشتر شبیه گلبولهای سفید طبیعی هستند) اما نه به طور کامل. این سلولها ممکن است نسبتاً طبیعی به نظر برسند، اما در واقعیت این طور نیستند. آنها معمولاً به اندازه گلبولهای سفید معمولی با عفونت مبارزه نمیکنند. سلولهای لوسمی بیشتر از سلولهای طبیعی زنده مانده و تجمع مییابند و سلولهای طبیعی در مغز استخوان را از بین میبرند. ممکن است زمان زیادی طول بکشد تا لوسمی مزمن مشکلاتی را برای فرد ایجاد کند و بیشتر افراد میتوانند سالها با آنها زندگی کنند. اما درمان لوسمیهای مزمن سختتر از لوسمیهای حاد (acute leukemias) است.
لوسمی لنفوسیتی (lymphocytic leukemia) چیست؟
سرطان خون بسته به اینکه سرطان در کدام سلولهای مغز استخوان شروع میشود، میلوئیدی (myeloid) یا لنفوسیتی است.
لوسمیهای لنفوسیتی (همچنین به عنوان لوسمی لنفوئیدی (lymphoid) یا لنفوبلاستیک (lymphoblastic) شناخته میشوند) در سلولهایی شروع میشوند که به لنفوسیت تبدیل میشوند. لنفومها (Lymphomas) نیز در واقع سرطانهایی هستند که در این سلولها شروع میشوند. تفاوت اصلی بین لوسمیهای لنفوسیتی و لنفوم در این است که در لوسمی، سلولهای سرطانی عمدتاً در مغز استخوان و خون هستند، در حالی که در لنفوم این سلولها در غدد لنفاوی و سایر بافتها قرار دارند.
انواع مختلف CLL
پزشکان در این موضوع هم عقیده هستند که به نظر میرسد 2 نوع مختلف CLL وجود دارد:
- یک نوع CLL بسیار کند رشد میکند. بنابراین ممکن است زمان زیادی طول بکشد تا بیمار نیاز به درمان داشته باشد.
- نوع دیگر CLL سریعتر رشد کرده و بیماری جدی تری است.
سلولهای لوسمی در این 2 نوع شبیه به هم هستند اما آزمایشهای آزمایشگاهی میتوانند تفاوت بین آنها را مشخص کنند. این آزمایشها به دنبال پروتئینهایی به نام ZAP-70 و CD38 هستند. اگر سلولهای CLL دارای مقادیر کمی از این پروتئینها باشند، سرطان خون آهستهتر رشد میکند و نتایج بلند مدت بهتری دارد.
اشکال نادر لوسمی لنفوسیتی
شکل رایج CLL در لنفوسیتهای B شروع میشود. اما برخی از انواع نادر لوسمی وجود دارد که برخی از ویژگیهای مشترک با CLL را دارند.
لوسمی پرولنفوسیتی (PLL یا Prolymphocytic leukemia): در این نوع لوسمی، سلولهای سرطانی بسیار شبیه سلولهای طبیعی به نام پرولنفوسیت هستند. این سلولها اشکال نابالغ لنفوسیتهای B (B-PLL) یا لنفوسیتهای T (T-PLL) هستند. هر دو B-PLL و T-PLL تمایل به رشد و گسترش سریعتر از نوع معمول CLL دارند. اکثر افراد مبتلا به این لوسمی به نوعی از درمان پاسخ میدهند اما با گذشت زمان تمایل به عود کردن بیماری دارند (سرطان عود میکند). PLL ممکن است در فردی ایجاد شود که قبلاً CLL داشته است (در این صورت بیماری تهاجمیتر است) اما در افرادی که هرگز CLL نداشتهاند نیز ممکن است رخ دهد.
لوسمی لنفوسیت دانهای بزرگ (LGL یا Large granular lymphocyte): این نوع نادر دیگری از لوسمی مزمن است. سلولهای سرطانی بزرگ بوده و دارای ویژگیهایی از لنفوسیتهای T یا نوع دیگری از لنفوسیتها به نام سلولهای کشنده طبیعی (NK یا natural killer) هستند. اکثر لوسمیهای LGL رشد آهسته دارند، اما تعداد کمی از آنها تهاجمی تر هستند (به سرعت رشد میکنند و پخش میشوند). داروهایی که سیستم ایمنی را سرکوب میکنند ممکن است در درمان این نوع کمک کننده باشند اما درمان انواع تهاجمی آن بسیار سخت است.
لوسمی سلول مویی (HCL یا Hairy cell leukemia): این سرطان نادر لنفوسیتها است که به کندی پیشرفت میکند. سلولهای سرطانی نوعی لنفوسیت B هستند اما با سلولهای CLL متفاوت هستند. همچنین تفاوتهای مهمی در علائم و روند درمان نیز وجود دارد. این نوع لوسمی نام خود را از شکل ظاهری سلولها در زیر میکروسکوپ گرفته است — آنها برجستگیهای ظریفی روی سطح خود دارند که آنها را “مودار (hairy)” میکند.
آمار کلیدی برای لوسمی لنفوسیتی مزمن
برآوردهای انجمن سرطان آمریکا برای لوسمی در ایالات متحده برای سال 2021 عبارتند از:
- حدود 61090 مورد جدید لوسمی و حدود 23660 مرگ ناشی از این بیماری (انواع آن)
- حدود 21250 مورد جدید لوسمی لنفوسیتی مزمن (CLL)
- حدود 4320 مرگ ناشی از CLL
CLL حدود یک چهارم موارد جدید لوسمی را تشکیل میدهد. میانگین خطر ابتلا به CLL در طول زندگی افراد حدود 1 در 175 (0.57 درصد) است. این خطر در مردان کمی بیشتر از زنان است.
CLL عمدتاً افراد مسن را تحت تأثیر قرار میدهد. میانگین سنی افراد در هنگام تشخیص این بیماری حدود 70 سال است. این سرطان به ندرت در افراد زیر 40 سال دیده میشود و در کودکان نیز بسیار نادر است.
علائم و نشانههای لوسمی لنفوسیتی مزمن
بسیاری از افراد مبتلا به لوسمی لنفوسیتی مزمن (CLL) هنگام تشخیص هیچ علامتی ندارند. لوسمی اغلب زمانی پیدا میشود که پزشک برای برخی از اختلالات سلامتی نامرتبط یا در طی معاینات معمول آزمایش خون تجویز کند و تعداد لنفوسیتهای آنها زیاد باشد.
حتی زمانی که افراد مبتلا به CLL علائمی دارند، این علائم اغلب مبهم هستند و میتوانند علائم چیزهای دیگری نیز باشند. علائم این سرطان میتواند شامل موارد زیر باشد:
- ضعف
- احساس خستگی
- کاهش وزن
- لرز
- تب
- تعریق شبانه
- تورم غدد لنفاوی (اغلب به صورت تودهای در زیر پوست احساس میشوند)
- درد یا احساس «پری» در شکم (این علامت میتواند باعث شود که فرد فقط بعد از یک وعده غذایی کوچک احساس سیری کند) که ناشی از بزرگ شدن طحال و یا کبد است.
بسیاری از علائم و نشانههای CLL پیشرفته به این دلیل رخ میدهد که سلولهای لوسمی جایگزین سلولهای طبیعی خون ساز مغز استخوان میشوند. در نتیجه، افراد گلبولهای قرمز کافی، گلبولهای سفید و پلاکتهای خونی که به درستی کار کنند، ندارند.
- کم خونی کمبود گلبولهای قرمز خون است. این وضعیت میتواند باعث خستگی، ضعف و تنگی نفس شود.
- کمبود گلبولهای سفید طبیعی (لکوپنی یا leukopenia) خطر عفونت را افزایش میدهد. ممکن است اصطلاح نوتروپنی (neutropenia) را بشنوید که به سطوح پایین نوتروفیلها (neutrophils) – نوعی گرانولوسیت (granulocyte) مورد نیاز برای مبارزه با عفونتهای باکتریایی – اشاره دارد. افراد مبتلا به CLL ممکن است به دلیل تعداد بیش از حد لنفوسیتها (لنفوسیتوز یا lymphocytosis) تعداد گلبولهای سفید خون بسیار بالایی داشته باشند اما سلولهای لوسمی مانند گلبولهای سفید معمولی با عفونت مبارزه نمیکنند.
- کمبود پلاکتهای خون (ترومبوسیتوپنی یا thrombocytopenia) میتواند منجر به کبودی زیاد، خونریزی، خونریزیهای مکرر یا شدید بینی و خونریزی لثه شود.
افراد مبتلا به CLL بیشتر در معرض خطر ابتلا به عفونت هستند. این اتفاق عمدتا به این دلیل است که سیستم ایمنی آنها آن طور که باید کار نمیکند. CLL سرطانی از لنفوسیتهای B است که به طور معمول آنتی بادیهایی میسازند که به مبارزه با عفونت کمک میکند. به دلیل CLL، این سلولهای آنتی بادی ساز آن طور که باید کار نمیکنند، بنابراین نمیتوانند با عفونتها مبارزه کنند. عفونتها ممکن است از چیزهای ساده مانند سرماخوردگی مکرر یا تبخال تا ذاتالریه و سایر عفونتهای جدی متغیر باشد.
CLL همچنین میتواند سیستم ایمنی را به روشهای دیگری تحت تاثیر قرار دهد. در برخی از افراد مبتلا به CLL، سلولهای سیستم ایمنی آنتی بادیهای غیر طبیعی میسازند که به سلولهای طبیعی خون حمله میکنند. این پدیده به عنوان خود ایمنی (autoimmunity) شناخته میشود و میتواند منجر به کاهش شمارش خون شود. اگر آنتی بادیها به گلبولهای قرمز خون حمله کنند، به آن کم خونی همولیتیک خودایمنی (autoimmune hemolytic anemia) میگویند. در موارد کمتر شایع، آنتی بادیها به پلاکتها و سلولهای سازنده آنها حمله میکنند که منجر به کاهش تعداد پلاکتها میشود. به ندرت، آنتی بادیها به گلبولهای سفید خون حمله میکنند که منجر به لکوپنی (تعداد کم گلبولهای سفید خون) میشود.
این علائم و نشانهها ممکن است ناشی از CLL باشند اما میتوانند ناشی از شرایط دیگری نیز باشند. با این حال، اگر هر یک از این مشکلات را دارید، مهم است که فوراً به پزشک مراجعه کنید تا بتوان علت را پیدا کرده و در صورت نیاز روند درمان را آغاز کرد.
آیا میدانیم چه چیزی باعث لوسمی لنفوسیتی مزمن میشود؟
علت دقیق اکثر موارد لوسمی لنفوسیتی مزمن (CLL) مشخص نیست. اما دانشمندان چیزهای زیادی در مورد تفاوت بین لنفوسیتهای طبیعی و سلولهای CLL آموخته اند.
سلولهای طبیعی انسان بر اساس اطلاعات کروموزومهای هر سلول رشد کرده و عمل میکنند. کروموزومها مولکولهای بلند DNA هستند. DNA ماده شیمیایی است که ژنهای (دستور العمل نحوه عملکرد سلولهای ما) ما را حمل میکند. ما شبیه والدین خود هستیم زیرا آنها منبع DNA ما هستند. اما ژنهای ما بر چیزی بیشتر از ظاهر ما تأثیر میگذارند.
هر بار که سلولی برای تقسیم شدن به 2 سلول جدید آماده میشود، باید یک کپی جدید از DNA در کروموزومهای خود بسازد. این فرآیند کامل نیست و ممکن است خطاهایی در طی آن رخ دهد که ممکن است بر ژنهای درون DNA تأثیر بگذارند.
برخی از ژنها حاوی دستورالعملهایی برای کنترل زمان رشد و تقسیم سلولهای ما هستند.
- ژنهای خاصی که باعث رشد و تقسیم سلولی میشوند، انکوژن (oncogenes) نامیده میشوند.
- ژنهایی که تقسیم سلولی را کند میکنند یا باعث مرگ سلولها در زمان مناسب میشوند، ژنهای سرکوب کننده تومور (tumor suppressor genes) نامیده میشوند.
سرطانها میتوانند به دلیل جهشهای DNA (تغییرات) ایجاد شوند که انکوژنها را فعال میکنند یا ژنهای سرکوب کننده تومور را خاموش میکنند.
هر سلول انسانی دارای 23 جفت کروموزوم است. در بیشتر موارد CLL، تغییر حداقل در یکی از این کروموزومها دیده میشود. اغلب این تغییر یک حذف (deletion) است – یعنی از دست دادن بخشی از یک کروموزوم. از بین رفتن بخشی از کروموزوم 13 شایع ترین حذف است اما کروموزومهای دیگر مانند 11 و 17 نیز میتوانند تحت تأثیر قرار گیرند.
ممکن است این حذفها را به صورت del(13q)، del(11q) یا del(17p) ببینید. گاهی اوقات یک کروموزوم 12 اضافی (تریزومی 12) وجود دارد. سایر ناهنجاریهای کمتر شایع نیز ممکن است، یافت شوند. دانشمندان میدانند که این تغییرات کروموزومی در CLL مهم هستند اما هنوز مشخص نیست که کدام ژنها را درگیر میکنند یا دقیقاً چگونه منجر به ایجاد سرطان خون میشوند.
ما میدانیم که لنفوسیتهای B طبیعی بخشی از سیستم ایمنی هستند. آنها طوری برنامه ریزی شده اند که در تماس با یک ماده خارجی به نام آنتی ژن رشد کرده و تقسیم شوند. (دانشمندان موادی (substances) را خارجی مینامند که به طور معمول در بدن فرد وجود نداشته باشد و توسط سیستم ایمنی بدن آنها نیز قابل تشخیص باشد. میکروبها حاوی آنتی ژنهای خارجی هستند. سلولهای خونی افراد دیگری با گروه خونی متفاوت نیز همینطور هستند.) دانشمندان فکر میکنند که CLL زمانی شروع میشود که لنفوسیتهای B پس از واکنش به آنتی ژن، بدون محدودیت به تقسیم خود ادامه میدهند. اما این که چرا این اتفاق میافتد، هنوز مشخص نیست.
گاهی اوقات افراد جهشهای DNA را از والدین خود به ارث میبرند که خطر ابتلا به انواع خاصی از سرطان را تا حد زیادی افزایش میدهد. اما جهشهای ارثی به ندرت باعث CLL میشوند. تغییرات DNA مربوط به CLL معمولاً در طول زندگی فرد رخ میدهد نه اینکه از والدین به فرد منتقل شده باشد.
عوامل خطرزا برای لوسمی لنفوسیتی مزمن چیست؟
یک عامل خطرزا چیزی است که بر شانس ابتلای فرد به بیماری مانند سرطان تأثیر میگذارد. سرطانهای مختلف عوامل خطرزای متفاوتی دارند. برخی از عوامل خطرزا مانند سیگار کشیدن را میتوان تغییر داد. سایر موارد، مانند سن یا سابقه خانوادگی فرد قابل تغییر نیستند.

اما عوامل خطرزا همه چیز را به ما نمیگوید. داشتن یک عامل خطرزا، یا حتی بسیاری از این عوامل، به این معنا نیست که شما به این بیماری مبتلا خواهید شد. برخی از افرادی که به این بیماری مبتلا میشوند ممکن است هیچ عامل خطرزای شناخته شده ای نداشته باشند. حتی اگر فردی دارای یک عامل خطرزا باشد و به سرطان مبتلا شود، اغلب بسیار سخت است که بفهمیم این عامل چقدر ممکن است در ایجاد این سرطان نقش داشته باشد.
عوامل خطرزا بسیار کمی برای لوسمی لنفوسیتی مزمن (CLL) وجود دارد. این عوامل شامل:
- سن
- قرار گرفتن در معرض مواد شیمیایی خاص
- سابقه خانوادگی
- جنسیت
- نژاد یا قومیت
به نظر نمیرسد خطر ابتلا به CLL با سیگار، رژیم غذایی یا عفونت مرتبط باشد.
سن
خطر ابتلا به CLL با افزایش سن افزایش مییابد. حدود 9 نفر از هر 10 نفر مبتلا به CLL بالای 50 سال سن دارند.
قرار گرفتن در معرض مواد شیمیایی خاص
برخی از مطالعات قرار گرفتن در معرض عامل نارنجی (Agent Orange) – یک علف کش مورد استفاده در طول جنگ ویتنام – را با افزایش خطر ابتلا به CLL مرتبط میدانند. برخی مطالعات دیگر نشان دادهاند که کشاورزی و قرار گرفتن طولانی مدت در معرض برخی از آفت کشها ممکن است با افزایش خطر ابتلا به CLL مرتبط باشد، اما برای اطمینان بیشتر از این فرضیه به تحقیقات بیشتری نیاز است.
قرار گرفتن در معرض رادون (Radon) در خانه با افزایش خطر ابتلا به بیماری مرتبط است.
سابقه خانوادگی
بستگان درجه یک (والدین، خواهر و برادر یا فرزندان) افراد مبتلا به CLL بیش از دو برابر خطر ابتلا به این سرطان را دارند.
جنسیت
CLL در مردان کمی بیشتر از زنان شایع است. دلایل این امر مشخص نیست.
نژاد یا قومیت
CLL در آمریکای شمالی و اروپا بیشتر از آسیا شایع است. آسیاییهایی که در ایالات متحده زندگی میکنند در مقایسه با کسانی که در آسیا زندگی میکنند، در معرض خطر بالاتری نیستند. به همین دلیل است که کارشناسان فکر میکنند تفاوت در این خطر به ژنتیک مربوط میشود تا عوامل محیطی.
لوسمی لنفوسیتی مزمن چگونه مرحله (سطح) بندی میشود؟
برای اکثر سرطانها، مرحله بندی فرآیندی است که مشخص میکند سرطان چقدر گسترش یافته است. این کار اغلب مفید است زیرا میتواند به هدایت کردن روند درمان و تعیین چشم انداز فرد کمک کنند. اکثر انواع سرطان بر اساس اندازه تومور و میزان گسترش سرطان مرحله بندی میشوند.
از طرف دیگر، لوسمی لنفوسیتی مزمن (CLL)، معمولاً تومور ایجاد نمیکند. این سرطان به طور کلی در مغز استخوان و خون است. در بسیاری از موارد، تا زمانی که بیماری تشخیص داده میشود، به سایر اندامها مانند طحال، کبد و غدد لنفاوی سرایت کرده است. چشم انداز یک فرد مبتلا به CLL به اطلاعات دیگری مانند نتایج آزمایشهای آزمایشگاهی و آزمایشهای تصویر برداری بستگی دارد.
سیستمهای مرحله بندی برای لوسمی لنفوسیتی مزمن
سیستم مرحله بندی روشی استاندارد برای تیم مراقبت از سرطان برای توصیف سرطان است. 2 سیستم مختلف برای مرحله بندی CLL وجود دارد:
- سیستم Rai: این سیستم بیشتر در ایالات متحده استفاده میشود.
- سیستم Binet: این سیستم بیشتر در اروپا استفاده میشود.
هر دوی این سیستمهای مرحله بندی مفید هستند و سالهاست که استفاده میشوند.
سیستم مرحله بندی رای (Rai)
سیستم Rai بر پایه لنفوسیتوز (lymphocytosis) است. بیمار باید تعداد زیادی لنفوسیت در خون و مغز استخوان خود داشته باشد که به هیچ علت دیگری (مانند عفونت) مرتبط نباشد.
برای تشخیص CLL، تعداد کلی لنفوسیتها نباید زیاد باشد اما بیمار باید حداقل در هر میلیمتر مکعب 5000 لنفوسیت مونوکلونال داشته باشد (که گاهی اوقات لنفوسیتوز مونوکلونال (monoclonal lymphocytosis) نامیده میشود). مونوکلونال به این معنی است که سلولهای سرطانی همه از یک سلول اصلی به وجود آمدهاند. این اتفاق باعث میشود که آنها دارای همان الگوی شیمیایی باشند که با آزمایشهای ویژه قابل مشاهده است.
این سیستم CLL را بر اساس نتایج آزمایش خون و معاینه فیزیکی بیماری را به 5 مرحله تقسیم میکند:
- Rai مرحله 0: لنفوسیتوز؛ عدم بزرگ شدن غدد لنفاوی، طحال یا کبد؛ تعداد گلبولهای قرمز و پلاکتها تقریباً طبیعی است.
- Rai مرحله I: لنفوسیتوز؛ غدد لنفاوی بزرگ شده؛ طحال و کبد بزرگ نشدهاند. تعداد گلبولهای قرمز و پلاکتها تقریباً طبیعی است.
- Rai مرحله Il: لنفوسیتوز؛ بزرگ شدن طحال (و شاید بزرگ شدن کبد)؛ غدد لنفاوی ممکن است بزرگ شده باشند یا نشده باشند. تعداد گلبولهای قرمز و پلاکتها تقریباً طبیعی است.
- Rai مرحله III: لنفوسیتوز؛ غدد لنفاوی، طحال یا کبد ممکن است بزرگ شوند یا نشوند. تعداد گلبولهای قرمز خون کم است (کم خونی). تعداد پلاکتها نزدیک به سطح نرمال یا طبیعی است.
- Rai مرحله IV: لنفوسیتوز؛ بزرگ شدن غدد لنفاوی، طحال یا کبد؛ تعداد گلبولهای قرمز ممکن است کم یا نزدیک به نرمال باشد. تعداد پلاکتها کم است (ترومبوسیتوپنی).
پزشکان هنگام تعیین گزینههای درمانی، مراحل Rai را به گروههای کم خطر، متوسط و پرخطر تقسیم میکنند.
- مرحله 0 کم خطر است.
- مراحل I و II دارای ریسک یا خطر متوسط هستند.
- مراحل III و IV پرخطر هستند.
این گروههای خطر بعداً در درمان لوسمی لنفوسیتی مزمن استفاده میشوند.
سیستم مرحله بندی بینت (Binet)
در سیستم مرحله بندی Binet، CLL بر اساس تعداد گروههای بافت لنفاوی آسیب دیده (گرههای لنفاوی گردن، غدد لنفاوی کشاله ران، غدد لنفاوی زیر بغل، طحال و کبد) و اینکه آیا بیمار کم خونی (گلبولهای قرمز بسیار کم) یا ترومبوسیتوپنی (پلاکتهای خون بسیار کم) دارد یا نه طبقه بندی میشود.
- مرحله Aبینت: کمتر از 3 ناحیه از بافت لنفوئیدی بزرگ شده است، بدون کم خونی یا ترومبوسیتوپنی.
- مرحله B بینت: 3 ناحیه یا بیشتر از بافت لنفوئیدی بزرگ شده است، بدون کم خونی یا ترومبوسیتوپنی.
- مرحله C بینت: کم خونی و یا ترومبوسیتوپنی وجود دارد. هر تعداد از مناطق بافت لنفاوی ممکن است بزرگ شود.
عوامل پیش بینی کننده برای لوسمی لنفوسیتی مزمن
در کنار مرحله سرطان، عوامل دیگری نیز وجود دارد که به پیش بینی وضعیت فرد کمک میکنند. این عوامل بخشی از سیستمهای مرحله بندی رسمی نیستند (حداقل در این زمان) اما اغلب هنگام بررسی گزینههای درمانی احتمالی در نظر گرفته میشوند.
- عواملی که تمایل دارند با زمان بقای کوتاه تری مرتبط باشند، عوامل پیش بینی کننده نامطلوب (adverse prognostic factors) نامیده میشوند.
- آنهایی که بقای طولانی تری را برای فرد پیش بینی میکنند، عوامل پیش بینی کننده مطلوب (favorable prognostic factors) هستند.
عوامل پیش بینی کننده نامطلوب
- الگوی درگیری منتشره مغز استخوان (جایگزینی گسترده تر مغز استخوان طبیعی با لوسمی)
- سن بالا
- حذف قسمتهایی از کروموزومهای 17 یا 11
- تریزومی 12 در سلولهای CLL
- سطوح بالای برخی از مواد مانند بتا-2-میکروگلوبولین (beta-2-microglobulin) در خون
- زمان دو برابر شدن لنفوسیتها (زمانی که طول میکشد تا تعداد لنفوسیتها دو برابر شود) کمتر از 1 سال
- افزایش نسبت پرولنفوسیتها (شکل اولیه لنفوسیت) در خون
- نسبت بالای سلولهای CLL حاوی ZAP-70 (20 درصد یا بیشتر) یا CD38 (30 درصد یا بیشتر)
- سلولهای CLL با ژن تغییر نیافته (جهش نیافته) در ناحیه متغیر زنجیره سنگین ایمونوگلوبولین (immunoglobulin heavy chain variable region یا IGHV)
- سلولهای CLL ژن TP53 را ندارند.
عوامل پیش بینی کننده مطلوب
- الگوی درگیری غیر منتشره (ندولار (nodular) یا بینابینی) مغز استخوان
- حذف بخشی از کروموزوم 13 (بدون هیچ گونه ناهنجاری در کروموزوم دیگری)
- نسبت کم سلولهای CLL حاوی ZAP-70 (کمتر از 20 درصد) یا CD38 (کمتر از 30 درصد)
- سلولهای CLL با ژن جهش یافته برای IGHV
برخی از عوامل پیش بینی کننده مانند وجود یا عدم وجود ZAP-70، CD38 و ژن جهش یافته برای IGHV به تقسیم موارد CLL به 2 گروه با رشد آهسته و رشد سریع کمک میکند. افراد مبتلا به نوع رشد کندتر CLL معمولا عمر طولانی تری دارند و همچنین ممکن است بتوانند روند درمان را برای مدت طولانی تری به تاخیر بیندازند.
مرحله بندی برای لوسمی سلول مویی
هیچ سیستم مرحله بندی استانداردی برای لوسمی سلول مویی وجود ندارد.
لنفوسیتوز B مونوکلونال
برخی افراد لنفوسیتهای مونوکلونال در خون خود دارند اما این سلولها برای تشخیص CLL کافی نیستند. اگر فردی کمتر از 5000 لنفوسیت مونوکلونال (در هر میلی متر مکعب)، تعداد طبیعی گلبولهای قرمز و پلاکتها و بزرگ شدن غدد لنفاوی (یا طحال بزرگ شده) داشته باشد، به وضعیتی به نام لنفوسیتوز B مونوکلونال (MBL) مبتلا میشود. MBL نیازی به درمان ندارد اما حدود یک بیمار از هر 100 بیمار مبتلا به این بیماری به درمان برای CLL نیاز دارد.
لنفوم لنفوسیتی کوچک (Small lymphocytic lymphoma)
سلولهای سرطانی لنفوم لنفوسیتی کوچک (SLL) و CLL در زیر میکروسکوپ یکسان به نظر میرسند و دارای پروتئینهای نشانگر یکسانی در سطح سلولها هستند. اینکه فردی مبتلا به SLL یا CLL تشخیص داده شود تا حد زیادی به تعداد لنفوسیتهای خون بستگی دارد. برای تشخیص CLL، باید حداقل 5000 لنفوسیت مونوکلونال (در هر میلیمتر مکعب) در خون وجود داشته باشد. برای اینکه به آن SLL گفته شود، بیمار باید غدد لنفاوی بزرگ شده یا طحال بزرگ شده با کمتر از 5000 لنفوسیت (در هر میلی متر مکعب) در خون داشته باشد. با این حال، از آن جایی که SLL و CLL را میتوان یکسان دانست، تفاوت بین آنها واقعاً مهم نیست.
آیا میتوان لوسمی لنفوسیتی مزمن را زود تشخیص داد؟
برای برخی از سرطانها، انجمن سرطان آمریکا آزمایشهای غربالگری را در افراد بدون هیچ علامتی توصیه میکند زیرا اگر زودتر تشخیص داده شوند، درمان آنها آسانتر است. اما برای لوسمی لنفوسیتی مزمن (CLL)، هیچ آزمایش غربالگری به طور معمول در این زمان توصیه نمیشود.
بسیاری از اوقات، CLL زمانی که آزمایشات معمولی خون به دلایل دیگری انجام میشوند، پیدا میشود.
به عنوان مثال، تعداد گلبولهای سفید خون یک فرد ممکن است بسیار بالا باشد، حتی اگر هیچ علامتی هم نداشته باشد.
اگر متوجه علائمی شدید که میتواند ناشی از CLL باشد، فوراً آن را به پزشک خود گزارش دهید تا در صورت نیاز بتوان علت را پیدا کرده و آن را درمان کرد.
لوسمی لنفوسیتی مزمن چگونه تشخیص داده میشود؟
برخی از علائم و نشانهها ممکن است نشان دهند که فرد مبتلا به لوسمی لنفوسیتی مزمن (CLL) است اما برای اطمینان از این مسئله آزمایشاتی لازم است.
تاریخچه پزشکی و معاینه فیزیکی
اگر امکان داشته باشد که سرطان خون داشته باشید، پزشک شما میخواهد یک تاریخچه پزشکی کامل از شما را برای بررسی علائم و عوامل خطر احتمالی بررسی کند. همچنین از شما در مورد سابقه پزشکی خانوادگی و سلامت عمومی شما سؤال میشود.
یک معاینه فیزیکی برای بررسی علائم احتمالی سرطان خون و سایر مشکلات سلامتی انجام خواهد شد. در طول معاینه، پزشک به غدد لنفاوی، شکم (belly) و سایر نواحی که ممکن است تحت تأثیر قرار بگیرند توجه زیادی خواهد کرد.
همچنین ممکن است پزشک آزمایشهایی را برای بررسی تعداد سلولهای خونی شما تجویز کند. اگر نتایج حاکی از وجود سرطان خون باشد، ممکن است به یک هماتولوژیست – پزشکی که در درمان اختلالات خونی (از جمله سرطانهای خون مانند لوسمی) متخصص است – ارجاع داده شوید. این پزشک ممکن است یک یا چند مورد از آزمایشاتی که در زیر توضیح داده شده است را انجام دهد.
آزمایشات مورد استفاده برای تشخیص و طبقه بندی لوسمی
برای اطمینان از تشخیص سرطان خون، باید آزمایشاتی روی خون و مغز استخوان شما انجام شود. سایر نمونههای بافتی و سلولی نیز ممکن است برای کمک به درمان مورد نیاز باشد.
آزمایشات خون
نمونه خون برای آزمایش CLL از ورید (سیاهرگ) بازوی شما گرفته میشود. تستهای مختلف زیادی انجام میشود.
شمارش کامل خون و آزمایش سلولهای خونی (اسمیر خون محیطی یا peripheral blood smear)
شمارش کامل خون یا CBC سلولهای مختلف خون شما مانند گلبولهای قرمز، گلبولهای سفید و پلاکتها را اندازه گیری میکند. این آزمایش اغلب همراه با یک بازه اختلافی (یا diff) انجام میشود که تعداد انواع مختلف گلبولهای سفید خون را بررسی میکند. این آزمایشات اغلب اولین آزمایشاتی هستند که در صورت مشکوک بودن به مشکلات خونی انجام میشوند.
افراد مبتلا به CLL تعداد زیادی لنفوسیت دارند. (این حالت ممکن است لنفوسیتوز (lymphocytosis) نامیده شود.) داشتن بیش از 10000 لنفوسیت در میلی متر مکعب خون (per cubic millimeter) خون به شدت نشان دهنده وجود CLL است اما آزمایشات دیگری برای اطمینان بیشتر مورد نیاز است. همچنین ممکن است سطح گلبولهای قرمز و پلاکت خون شما پایین باشد.
نمونه ای از خون زیر میکروسکوپ بررسی میشود (به نام اسمیر خون محیطی). اگر مبتلا به CLL هستید، اسمیر خون میتواند بسیاری از لنفوسیتهای غیر طبیعی به نام سلولهای لکه (smudge cells) را نشان دهد.
فلوسیتومتری (Flow cytometry)
این آزمایش در تشخیص CLL مهم است. از دستگاهی استفاده میکند که به دنبال مواد خاصی (نشانگرها) روی سلولها یا درون سلولها میگردد که به شناسایی انواع سلولها کمک میکند.
از این آزمایش میتوان برای مشاهده اینکه آیا لنفوسیتهای موجود در نمونه خون حاوی سلولهای CLL هستند یا خیر، استفاده کرد. فلوسیتومتری همچنین میتواند برای جستجوی سلولهای CLL در مغز استخوان یا مایعات دیگر استفاده شود.
فلوسیتومتری همچنین میتواند برای آزمایش وجود موادی به نام ZAP-70 و CD38 بر روی سلولهای CLL استفاده شود. مطالعات نشان میدهد که به نظر میرسد افرادی که CLL کمتری که حاوی مواد هستند، داشته باشند چشم انداز بهتری دارند. این موضوغ با جزئیات بیشتر در مراحل لوسمی لنفوسیتی مزمن مورد بحث قرار گرفته است.
سایر آزمایشات خون
آزمایشهای دیگری ممکن است برای اندازه گیری مقدار مواد شیمیایی خاص در خون شما انجام شوند اما از آنها برای تشخیص سرطان خون استفاده نمیشود. در افرادی که قبلاً به CLL مبتلا هستند، این آزمایشها میتواند به یافتن مشکلات کبدی یا کلیوی ناشی از گسترش سلولهای سرطان خون یا داروهای شیمی درمانی خاص (chemo) کمک کند. این آزمایشها همچنین میتوانند سطوح برخی از مواد معدنی را بررسی کنند تا هرگونه عدم تعادل قابل درمان باشد. اگر قرار است با داروی ریتوکسیماب (Rituxan یا rituximab) درمان شوید، ممکن است پزشک آزمایش خون را برای بررسی عفونت قبلی ناشی از هپاتیت تجویز کند.
سطح ایمونوگلوبولین یا immunoglobulin (آنتی بادی) خون شما ممکن است برای بررسی اینکه آیا آنتی بادی کافی برای مبارزه با عفونتها را دارید، به خصوص اگر اخیراً عفونتهای زیادی داشته اید، آزمایش شود. پروتئین خونی دیگری به نام بتا-2-میکروگلوبولین (beta-2-microglobulin) ممکن است اندازه گیری شود. سطوح بالای این پروتئین به طور کلی به معنای CLL پیشرفته تر است.
آزمایشات مغز استخوان
آزمایش خون اغلب برای تشخیص CLL کافی است اما آزمایش مغز استخوان میتواند به پیشرفت آن کمک کند. به همین دلیل، آزمایشات مغز استخوان اغلب قبل از شروع روند درمان انجام میشود. همچنین ممکن است در طول یا بعد از روند درمان تکرار شود تا ببینند آیا درمان موثر بوده است یا خیر.
آسپیراسیون مغز استخوان (Bone marrow aspiration) و بیوپسی (biopsy) یا نمونه برداری برای گرفتن نمونههای مغز استخوان برای آزمایش انجام میشود. آنها معمولا با هم انجام میشوند. نمونهها معمولاً از پشت استخوان لگن (hip) گرفته میشوند اما گاهی اوقات ممکن است از استخوانهای دیگری نیز نمونه برداری شود.
برای آسپیراسیون مغز استخوان، روی یک میز دراز میکشید (به پهلو یا روی شکم). پس از تمیز کردن پوست لگن، پزشک با استفاده از یک سوزن نازک بلند، دارویی را به بدن وارد میکند که ناحیه و سطح استخوان را بیحس میکند. این کار ممکن است باعث سوزش یا سوزش مختصر شود. سپس یک سوزن تو خالی در استخوان گذاشته میشود و از یک سرنگ برای مکیدن مقدار کمی (حدود 1 قاشق چایخوری) از مغز استخوان غلیظ و مایع استفاده میشود.
حتی با استفاده از داروی بی حس کننده، اکثر افراد هنوز در هنگام برداشتن مغز استخوان درد مختصری دارند.
بیوپسی مغز استخوان معمولاً درست بعد از آسپیراسیون انجام میشود. یک قطعه کوچک (core) استخوان و مغز آن (حدود ۱۶/۱ اینچ قطر و ۲/۱ اینچ طول) با یک سوزن بزرگتر که در حین فشار دادن به استخوان به سمت پایین پیچیده میشود، برداشته میشود. حتی با داروی بی حس کننده، این کار میتواند باعث احساس فشار یا کشش شود اما معمولاً درد ندارد. پس از انجام بیوپسی، برای جلوگیری از خونریزی به محل فشار وارد میشود.
معاینات معمول میکروسکوپی
یک پاتولوژیست (پزشک متخصص در آزمایشات آزمایشگاهی) به نمونههای مغز استخوان در زیر میکروسکوپ نگاه میکند. آنها همچنین ممکن است توسط هماتولوژیست یا انکولوژیست شما (پزشک متخصص در بیماریهای خونی و سرطان) نیز بررسی شوند.
پزشکان به اندازه، شکل و سایر ویژگیهای گلبولهای سفید در نمونهها توجه خواهند کرد. این کار به دسته بندی سلولها به انواع خاصی کمک میکند.
یک عامل مهم این است که سلولها بالغ به نظر میرسند (مانند سلولهای خونی طبیعی که میتوانند با عفونتها مبارزه کنند). سلولهای CLL معمولا بالغ به نظر میرسند در حالی که سلولهای لوسمی حاد نابالغ به نظر میرسند.
یکی از ویژگیهای کلیدی نمونه مغز استخوان، سلولی بودن یا آرایش سلولی آن است. مغز استخوان نرمال دارای تعداد مشخصی سلولهای خون ساز و سلولهای چربی است. گفته میشود مغز استخوان با سلولهای خون ساز بیش از حد، هیپرسلولار (hypercellular) نامیده میشود. این پدیده اغلب در مغز استخوان یک فرد مبتلا به CLL دیده میشود. پزشکان همچنین به دنبال این هستند که ببینند چه مقدار از سلولهای طبیعی در مغز استخوان با سلولهای CLL جایگزین میشوند.
الگوی انتشار سلولهای CLL در مغز استخوان نیز مهم است. الگویی که در آن سلولها در گروههای کوچک قرار دارند (به نام الگوی گرهای (nodular) یا بینابینی (interstitial))، اغلب به معنای چشم انداز بهتری نسبت به پراکندگی سلولها در سراسر مغز است (الگوی منتشره یا diffuse).
رنگها و یا آزمایشهای آنتی بادی مانند سیتوشیمی (cytochemistry)، ایمونوسیتوشیمی (immunocytochemistry)، ایمونوهیستوشیمی (immunohistochemistry) و فلوسیتومتری ممکن است بر روی نمونههای مغز استخوان برای تشخیص CLL استفاده شود. میتوانید در تستهای مورد استفاده در نمونههای بیوپسی و سیتولوژی برای تشخیص سرطان، درباره این آزمایشها اطلاعات بیشتری کسب کنید.
آزمایشات ژنی
سیتوژنتیک (Cytogenetics)
برای این آزمایش، سلولهای مغز استخوان (یا گاهی اوقات سلولهایی از خون یا سایر بافتها) در آزمایشگاه رشد میکنند، سپس کروموزومهای آنها زیر میکروسکوپ بررسی میشوند. از آن جایی که شروع فرآیند تقسیم سلولها زمان میبرد، این آزمایش معمولاً هفتهها طول میکشد. سلولهای طبیعی انسان حاوی 23 جفت کروموزوم هستند اما گاهی اوقات سلولهای CLL تغییرات کروموزومی دارند که در زیر میکروسکوپ قابل مشاهده است.
در برخی موارد CLL، ممکن است بخشی از یک کروموزوم از بین رفته باشد. به این پدیده حذف (deletion) میگویند. شایع ترین حذفها در قسمتهایی از کروموزومهای 13، 11 یا 17 رخ میدهد. حذف بخشی از کروموزوم 17 با چشم انداز ضعیفی مرتبط است. سایر تغییرات کروموزوم کمتر رایج شامل یک کپی اضافی از کروموزوم 12 (تریزومی 12) یا جابجایی (تبادل DNA یا translocation) بین کروموزومهای 11 و 14 [نوشته شده به صورت t(11;14)] است.
این اطلاعات ممکن است برای تعیین وضعیت آتی (چشم انداز) بیمار مفید باشد اما باید همراه با عوامل دیگری مانند مرحله CLL، بررسی شود. از دست دادن بخشی از کروموزوم 13 معمولاً با یک بیماری با رشد کندتر و چشم انداز بهتر مرتبط است، در حالی که نقص در کروموزومهای 11 یا 17 اغلب نشان دهنده چشم انداز ضعیف تر است. به نظر نمیرسد تریزومی 12 تأثیر زیادی بر پیش بینی وضعیت بیمار داشته باشد.
هیبریداسیون در محل فلورسنت (FISH)
از این آزمایش کروموزومی میتوان برای بررسی کروموزومها و DNA سلولها بدون نیاز به رشد سلولها در آزمایشگاه استفاده کرد. این روش از رنگهای فلورسنت خاصی استفاده میکند که فقط به قسمتهای خاصی از کروموزومهای خاصی متصل میشوند. FISH برای جستجوی ژنها یا تغییرات کروموزومی خاص (نه هر تغییری) استفاده میشود. میتوان از آن در نمونههای معمولی خون یا مغز استخوان نیز استفاده کرد. از آن جایی که سلولها مجبور نیستند ابتدا در آزمایشگاه رشد کنند، معمولاً میتوانید نتایج را سریعتر از سیتوژنتیک و اغلب در عرض چند روز دریافت کنید.
آزمایشات مولکولی
ایمونوگلوبولینها (Immunoglobulins) – آنتی بادیهایی که به بدن شما در مبارزه با عفونتها کمک میکنند – از زنجیرههای سبک و زنجیرههای سنگین تشکیل شدهاند. اینکه آیا ژن ناحیه متغیر زنجیره سنگین ایمونوگلوبولین (IGHV یا IgVH) تغییر کرده است (جهش یافته) میتواند به پزشک کمک کند تا بفهمد CLL شما چقدر تهاجمی است. این ژن در آزمایشی به نام توالی cDNA بررسی میشود.
بیوپسی غدد لنفاوی
در بیوپسی غدد لنفاوی، تمام یا بخشی از یک غدد لنفاوی برداشته میشود تا بتوان آن را زیر میکروسکوپ بررسی کرد تا ببیند آیا سلولهای سرطانی در آن وجود دارد یا خیر. این آزمایش اغلب برای تشخیص لنفوم (lymphomas) انجام میشود اما به ندرت برای CLL مورد نیاز است. اگر یکی از غدد لنفاوی بسیار بزرگ شده باشد و پزشک بخواهد بفهمد که آیا لوسمی به یک لنفوم تهاجمیتر تغییر کرده (تبدیل شده)، این آزمایش ممکن است انجام شود.
در بیوپسی غدد لنفاوی برشی (excisional lymph node biopsy)، کل غده لنفاوی از طریق بریدگی در پوست برداشته میشود. اگر گره نزدیک سطح پوست باشد، این یک عمل ساده است که میتوان برای انجام آن ابتدا پوست را بی حس کرد اما اگر گره داخل قفسه سینه یا شکم (belly) باشد، از بیهوشی عمومی (حالتی که بیمار به خواب میرود) استفاده میشود. اگر غده لنفاوی خیلی بزرگ باشد، ممکن است تنها بخشی از آن برداشته شود. به این عمل بیوپسی برشی (incisional biopsy) میگویند.
سوراخ کمری (spinal tap)
این روش برای آزمایش مایعی که مغز و نخاع را احاطه کرده است (مایع مغزی نخاعی یا CSF) استفاده میشود. این روش اغلب برای افراد مبتلا به CLL مورد نیاز نیست و تنها در صورتی انجام میشود که پزشک مشکوک باشد که سلولهای سرطانی خون ممکن است به ناحیه اطراف مغز یا نخاع گسترش یافته باشند (که حالتی نادر است) یا اگر ممکن است عفونتی در آن نواحی وجود داشته باشد.
برای این آزمایش، پزشک ابتدا ناحیهای در قسمت پایین کمر را روی ستون فقرات بی حس میکند. سپس یک سوزن کوچک و تو خالی بین استخوانهای ستون فقرات و در فضای اطراف نخاع قرار داده میشود تا مقداری از مایع را جمع کند.
تستهای تصویر برداری
تستهای تصویربرداری از اشعه ایکس، امواج صوتی یا میدانهای مغناطیسی برای ایجاد تصاویری از داخل بدن استفاده میکنند. آزمایشات تصویر برداری برای تشخیص CLL انجام نمیشود اما ممکن است به دلایل دیگری انجام شود؛ به عنوان مثال برای کمک به یافتن ناحیه مشکوکی که ممکن است سرطانی باشد برای اطلاع از میزان گسترش سرطان یا کمک به بررسی موثر بودن روند درمان.
توموگرافی کامپیوتری (Computed tomography یا CT) اسکن
سی تی اسکن میتواند به بزرگ شدن غدد لنفاوی یا اندامهای بدن شما کمک کند. این آرمایش معمولاً برای تشخیص CLL نیازی نیست اما اگر پزشک مشکوک باشد که سرطان خون در اندامی مانند طحال شما در حال رشد است، ممکن است انجام شود.
گاهی اوقات سی تی اسکن با اسکن PET در آزمایشی که به نام PET/CT اسکن شناخته میشود، ترکیب میشود. برای اسکن PET، گلوکز (نوعی قند) حاوی یک اتم رادیو اکتیو به خون تزریق میشود. از آن جایی که سلولهای سرطانی به سرعت رشد میکنند، مقادیر زیادی قند رادیو اکتیو را جذب میکنند. سپس یک دوربین مخصوص میتواند تصویری از مناطق پرتوزا در بدن ایجاد کند. اسکن PET/CT هر دو آزمایش را در یک دستگاه ترکیب میکند. این آزمایش به پزشک این امکان را میدهد که نواحی با رادیواکتیویته بالاتر در اسکن PET را با ظاهر دقیق آن ناحیه در CT مقایسه کند.
اسکن تصویربرداری رزونانس مغناطیسی (MRI یا Magnetic resonance imaging)
اسکن MRI برای بررسی مغز و نخاع بسیار مفید است اما اغلب در افراد مبتلا به CLL مورد نیاز نیست.
سونوگرافی (Ultrasound)
از سونوگرافی میتوان برای مشاهده غدد لنفاوی نزدیک سطح بدن یا برای جستجوی اندامهای بزرگ شده (مانند کبد و طحال) در داخل شکم استفاده کرد.
رسیدگیهای درمانی
گزینههای درمانی شما برای لوسمی لنفوسیتی مزمن به عوامل متعددی مانند مرحله سرطان، اینکه آیا علائم و نشانههایی را تجربه میکنید، سلامت کلی و ترجیحات شما بستگی دارد.
ممکن است فوراً نیازی به درمان نباشد
اگر لوسمی لنفوسیتی مزمن شما علائمی ایجاد نمیکند و علائم بدتر شدن را نشان نمیدهد، ممکن است نیازی به درمان فوری نداشته باشید. مطالعات نشان دادهاند که درمان زود هنگام عمر افراد مبتلا به لوسمی لنفوسیتی مزمن در مراحل اولیه را افزایش نمیدهد.
پزشکان به جای اینکه شما را در معرض عوارض جانبی و عوارض احتمالی روند درمان قبل از اینکه اصلا نیازی به آن داشته باشید، قرار دهند به دقت وضعیت شما را زیر نظر میگیرند و درمان را برای زمانی که سرطان خون شما پیشرفت میکند، به تعویق میاندازند.
پزشک شما یک برنامه چکاپ (checkup schedule) را برای شما برنامه ریزی میکند. شما ممکن است با پزشک خود ملاقات کرده و هر چند ماه یکبار آزمایش خون خود را برای نظارت بر وضعیتتان انجام دهید.
روندهای درمانی برای مراحل متوسط و پیشرفته
اگر پزشک تشخیص دهد که لوسمی لنفوسیتی مزمن شما نیاز به درمان دارد، گزینههای درمانی شما ممکن است شامل موارد زیر باشند:
- شیمی درمانی (Chemotherapy): شیمی درمانی یک درمان دارویی است که سلولهای در حال رشد سریع از جمله سلولهای سرطانی را از بین میبرد. داروهای شیمی درمانی را میتوان از طریق ورید یا به شکل قرص مصرف کرد. بسته به شرایط شما، پزشک ممکن است از یک داروی شیمی درمانی استفاده کند یا ممکن است ترکیبی از داروها را برای شما تجویز کند.
- درمان دارویی هدفمند (Targeted drug therapy): درمانهای دارویی هدفمند بر روی ناهنجاریهای خاص موجود در سلولهای سرطانی تمرکز دارند. با مسدود کردن این ناهنجاریها، درمانهای دارویی هدفمند میتوانند باعث مرگ سلولهای سرطانی شوند.
- ایمونوتراپی (Immunotherapy): ایمونوتراپی از سیستم ایمنی بدن شما برای مبارزه با سرطان استفاده میکند. سیستم ایمنی بدن شما که با بیماری مبارزه میکند ممکن است به سرطان شما حمله نکند زیرا سلولهای سرطانی پروتئینهایی تولید میکنند که به آنها کمک میکند تا از سلولهای سیستم ایمنی پنهان شوند. ایمونوتراپی با تداخل در این فرآیند کار میکند.
- پیوند مغز استخوان (Bone marrow transplant): پیوند مغز استخوان که به عنوان پیوند سلولهای بنیادی (stem cell transplant) نیز شناخته میشود، از داروهای شیمی درمانی قوی برای از بین بردن سلولهای بنیادی در مغز استخوان شما که لنفوسیتهای بیمار را ایجاد میکنند، استفاده میکند. سپس سلولهای بنیادی خون بالغ سالم از یک اهدا کننده به خون شما تزریق میشود.در این حالت، آنها به مغز استخوان شما میروند و شروع به ساخت سلولهای خونی سالم میکنند.
با توسعه ترکیبات دارویی جدید و موثرتر، پیوند مغز استخوان در درمان لوسمی لنفوسیتی مزمن کمتر رایج شده است. با این حال، در شرایط خاص این روش ممکن است یک گزینه درمانی باشد.
روندهای درمانی ممکن است به تنهایی یا در ترکیب با یکدیگر استفاده شوند.
مطالعه صدها مطلب علمی در حوزه بیولوژی
آرشیو جدیدترین خبرهای روز دنیای بیولوژی
مترجم: فاطمه فریادرس





